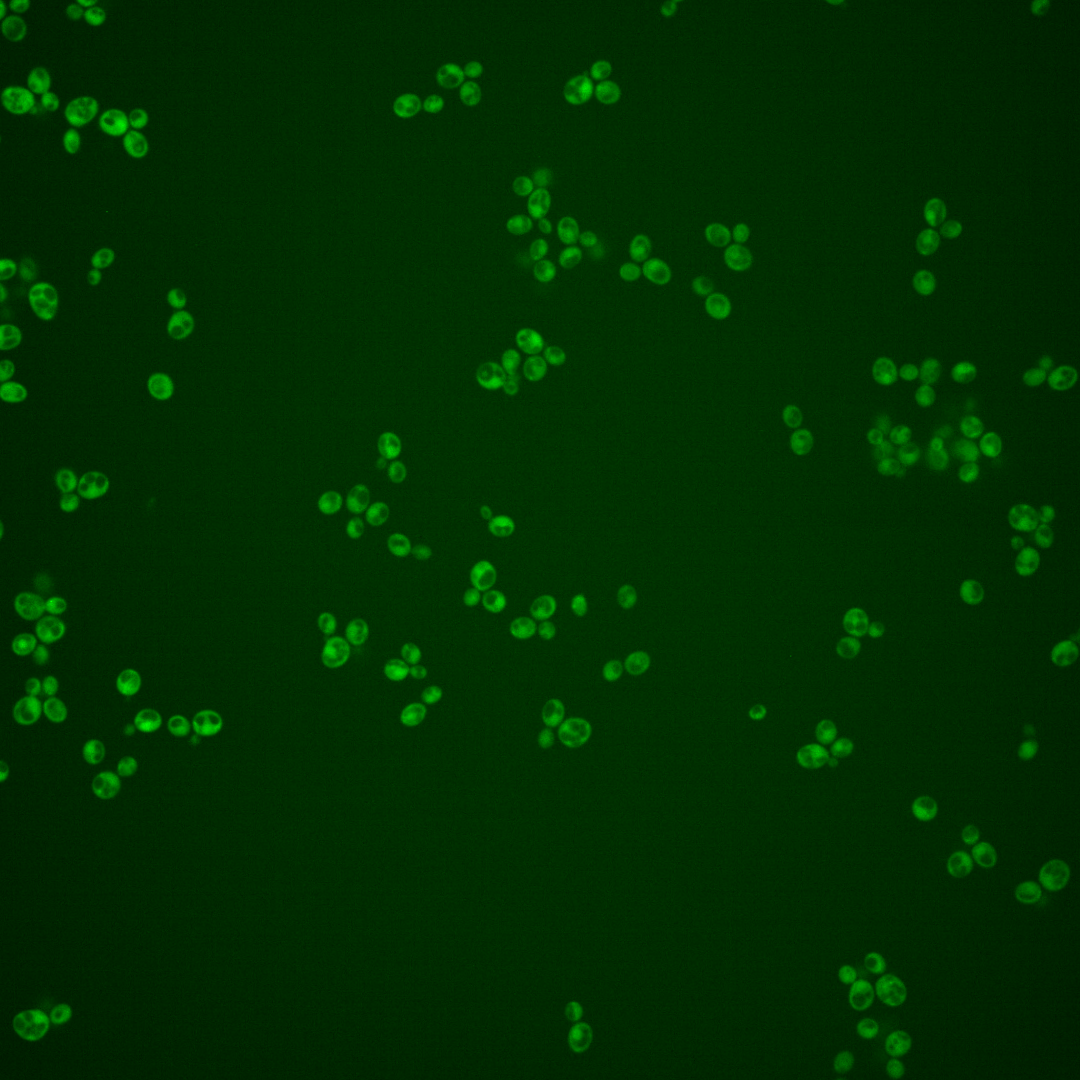
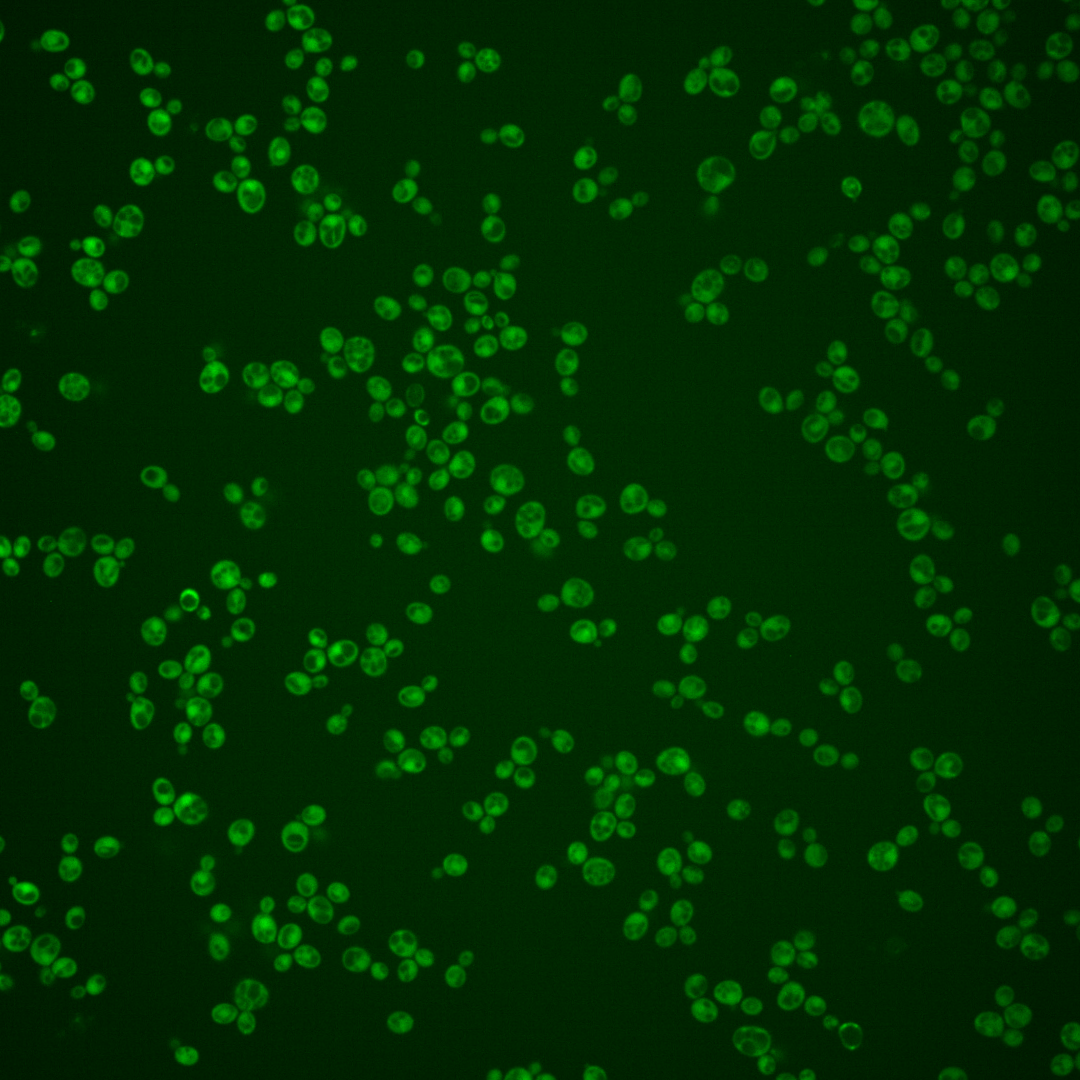
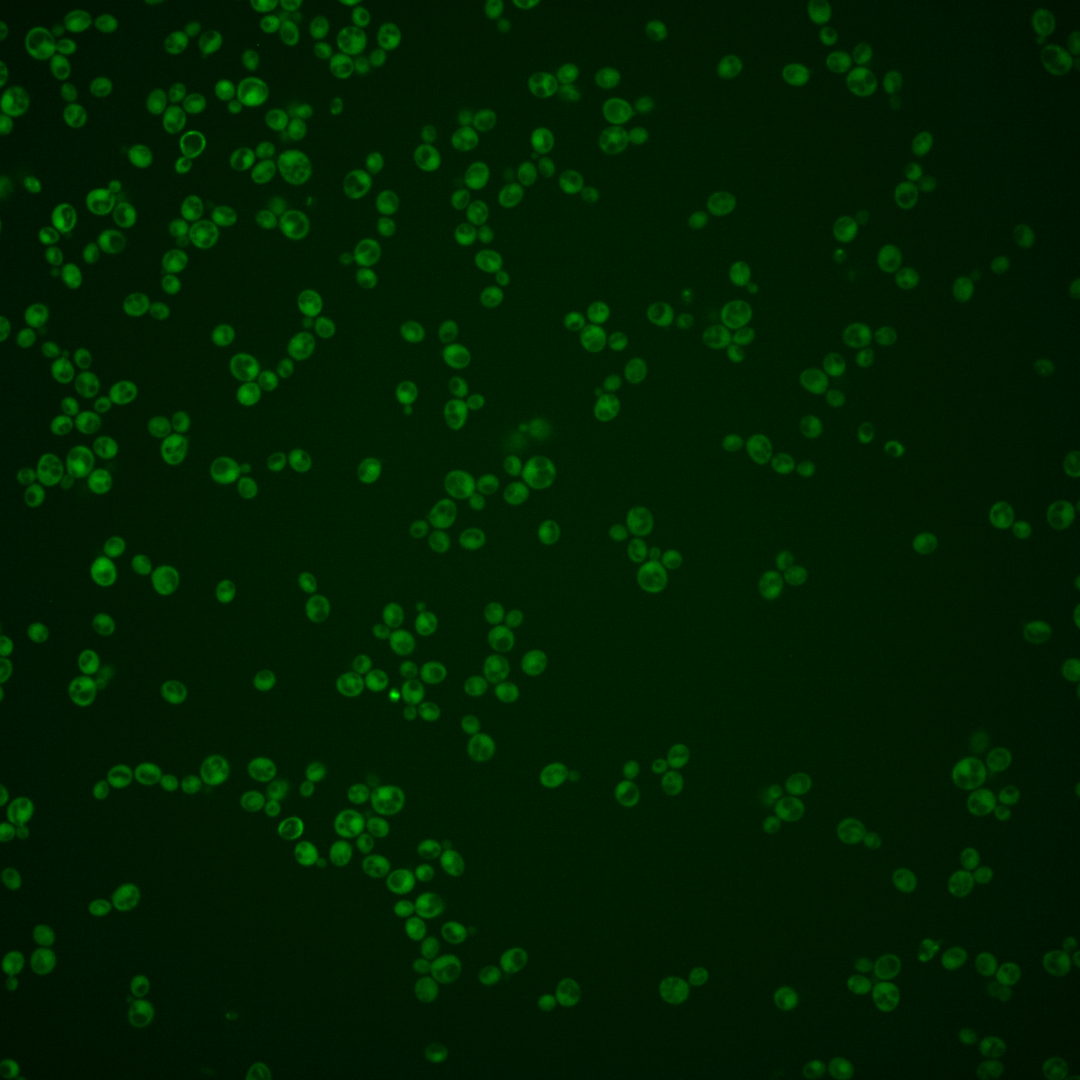
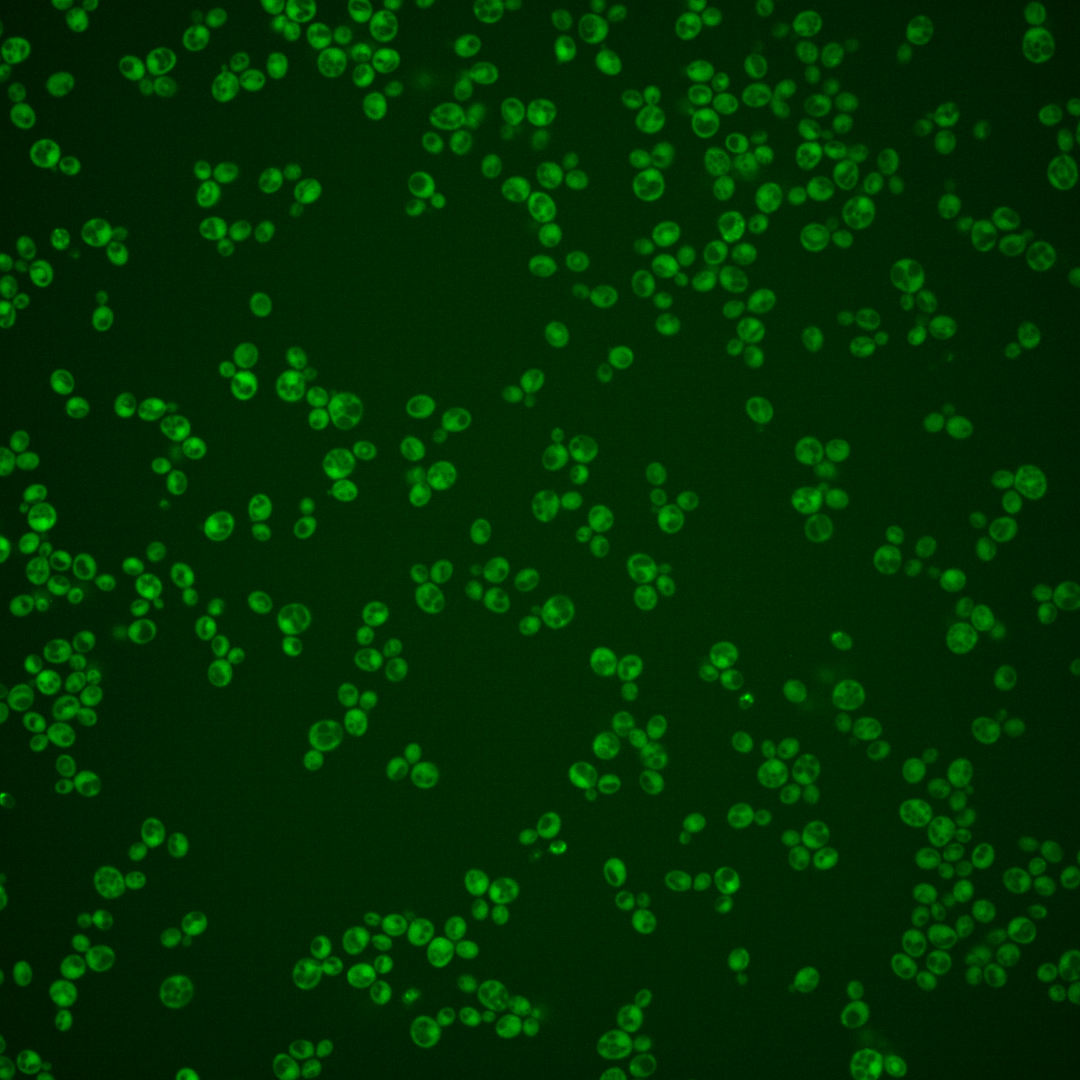
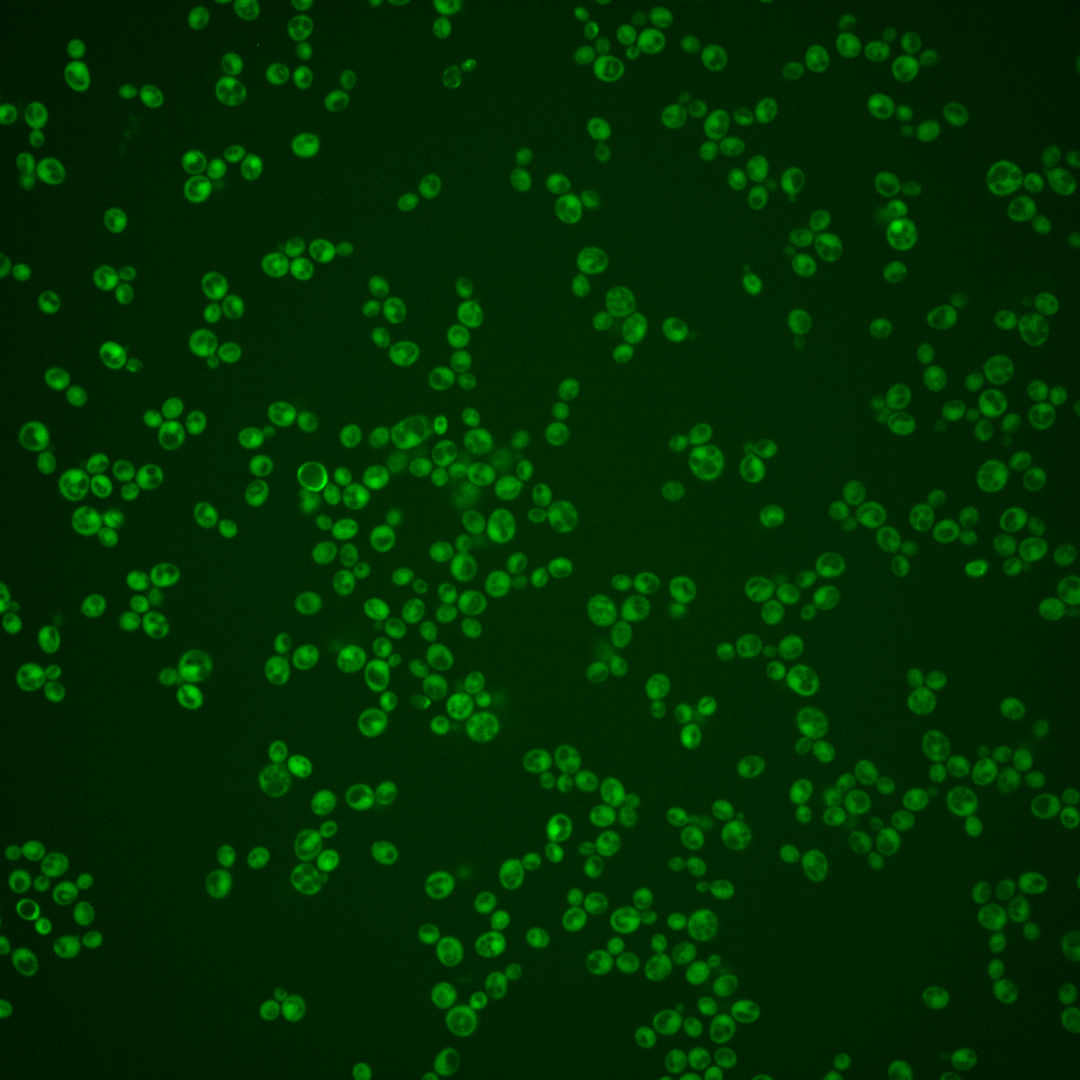

| ORF | |
|---|---|
| Human Ortholog | |
| Description | Putative protein of unknown function; conserved across S. cerevisiae strains; deletion confers sensitivity to citric acid; predicted protein would include a thiol-disulfide oxidoreductase active site |
Micrographs




















































































Sub-cellular Localization
Yeast GFP Assignment
Protein Abundance
Localization Change
External localization resources
| ensLOC | DeepLoc | |||||||||||||||||||||||
|---|---|---|---|---|---|---|---|---|---|---|---|---|---|---|---|---|---|---|---|---|---|---|---|---|
| Localization | WT1 | WT2 | WT3 | RAP60 | RAP140 | RAP220 | RAP300 | RAP380 | RAP460 | RAP540 | RAP620 | RAP700 | HU80 | HU120 | HU160 | rpd3Δ_1 | rpd3Δ_2 | rpd3Δ_3 | WT1 | WT2 | WT3 | AF100 | AF140 | AF180 |
| Cortical Patches | 0 | 0 | 0 | 0 | 0 | 1 | 0 | 0 | 0 | 0 | 0 | 0 | 0 | 0 | 0 | 0 | 0 | 0 | 0 | 0 | 0 | 0 | 1 | 1 |
| Bud | 2 | 1 | 1 | 3 | 2 | 2 | 7 | 6 | 3 | 7 | 12 | 8 | 0 | 1 | 0 | 1 | 0 | 0 | 5 | 1 | 1 | 1 | 2 | 9 |
| Bud Neck | 0 | 0 | 0 | 0 | 0 | 0 | 0 | 0 | 0 | 1 | 0 | 0 | 0 | 0 | 0 | 0 | 0 | 0 | 0 | 0 | 0 | 0 | 0 | 2 |
| Bud Site | 0 | 0 | 0 | 0 | 0 | 0 | 0 | 0 | 1 | 0 | 2 | 1 | 0 | 0 | 0 | 0 | 0 | 0 | – | – | – | – | – | – |
| Cell Periphery | 0 | 1 | 0 | 0 | 2 | 2 | 4 | 5 | 1 | 2 | 2 | 4 | 0 | 1 | 0 | 5 | 10 | 4 | 0 | 0 | 0 | 0 | 0 | 0 |
| Cytoplasm | 475 | 201 | 68 | 302 | 419 | 363 | 540 | 600 | 301 | 339 | 294 | 353 | 424 | 516 | 597 | 122 | 163 | 178 | 473 | 195 | 79 | 93 | 384 | 513 |
| Endoplasmic Reticulum | 0 | 0 | 0 | 1 | 1 | 1 | 1 | 0 | 0 | 1 | 1 | 0 | 3 | 1 | 4 | 4 | 5 | 8 | 0 | 0 | 0 | 0 | 1 | 2 |
| Endosome | 1 | 0 | 0 | 1 | 1 | 1 | 0 | 4 | 1 | 1 | 1 | 1 | 0 | 0 | 0 | 1 | 0 | 1 | 0 | 0 | 2 | 1 | 1 | 6 |
| Golgi | 0 | 0 | 0 | 0 | 0 | 0 | 0 | 0 | 0 | 0 | 0 | 0 | 1 | 0 | 0 | 0 | 1 | 1 | 1 | 0 | 0 | 0 | 2 | 2 |
| Mitochondria | 1 | 0 | 5 | 27 | 14 | 91 | 196 | 255 | 213 | 238 | 232 | 302 | 2 | 1 | 0 | 2 | 3 | 0 | 1 | 1 | 0 | 0 | 2 | 9 |
| Nucleus | 2 | 1 | 1 | 0 | 2 | 0 | 7 | 15 | 9 | 6 | 11 | 8 | 1 | 1 | 1 | 2 | 0 | 3 | 1 | 0 | 0 | 0 | 2 | 0 |
| Nuclear Periphery | 1 | 0 | 0 | 0 | 0 | 0 | 4 | 0 | 3 | 0 | 4 | 5 | 0 | 0 | 1 | 0 | 0 | 0 | 0 | 0 | 0 | 0 | 0 | 0 |
| Nucleolus | 0 | 0 | 0 | 4 | 0 | 0 | 1 | 4 | 1 | 1 | 3 | 1 | 1 | 0 | 0 | 0 | 0 | 0 | 0 | 0 | 0 | 0 | 0 | 0 |
| Peroxisomes | 0 | 0 | 0 | 0 | 0 | 0 | 0 | 1 | 0 | 0 | 0 | 0 | 0 | 0 | 0 | 0 | 0 | 0 | 0 | 0 | 0 | 0 | 0 | 0 |
| SpindlePole | 0 | 0 | 0 | 0 | 0 | 0 | 0 | 1 | 0 | 1 | 0 | 0 | 0 | 0 | 0 | 0 | 0 | 0 | 1 | 0 | 0 | 1 | 1 | 3 |
| Vac/Vac Membrane | 1 | 1 | 0 | 3 | 15 | 6 | 28 | 69 | 33 | 19 | 19 | 27 | 1 | 1 | 2 | 14 | 13 | 7 | 0 | 2 | 0 | 0 | 4 | 6 |
| Unique Cell Count | 478 | 202 | 70 | 315 | 432 | 402 | 673 | 803 | 438 | 491 | 448 | 560 | 431 | 521 | 605 | 131 | 174 | 185 | 489 | 202 | 89 | 99 | 407 | 563 |
| Labelled Cell Count | 483 | 205 | 75 | 341 | 456 | 467 | 788 | 960 | 566 | 616 | 581 | 710 | 433 | 522 | 605 | 151 | 195 | 202 | 489 | 202 | 89 | 99 | 407 | 563 |
Yeast GFP Assignment
Protein Abundance
| Screen | WT1 | WT2 | WT3 | RAP60 | RAP140 | RAP220 | RAP300 | RAP380 | RAP460 | RAP540 | RAP620 | RAP700 | HU80 | HU120 | HU160 | rpd3Δ_1 | rpd3Δ_2 | rpd3Δ_3 | AF100 | AF140 | AF180 |
|---|---|---|---|---|---|---|---|---|---|---|---|---|---|---|---|---|---|---|---|---|---|
| Mean Cell GFP Intensity (1e-4) | 6.3 | 7.4 | 4.1 | 5.1 | 5.6 | 4.5 | 4.3 | 4.5 | 4.0 | 4.1 | 3.9 | 3.9 | 7.0 | 7.5 | 7.0 | 8.6 | 8.9 | 8.3 | 6.2 | 6.8 | 6.7 |
| Std Deviation (1e-4) | 1.0 | 2.7 | 1.3 | 1.3 | 1.4 | 1.1 | 1.2 | 1.0 | 1.2 | 0.8 | 1.2 | 0.8 | 1.5 | 1.5 | 1.3 | 1.5 | 1.8 | 1.4 | 1.2 | 1.3 | 1.4 |
| Intensity Change (Log2) | – | – | – | 0.31 | 0.45 | 0.13 | 0.08 | 0.13 | -0.04 | -0.01 | -0.06 | -0.09 | 0.76 | 0.87 | 0.78 | 1.06 | 1.11 | 1.03 | 0.6 | 0.73 | 0.71 |
Localization Change
| Localization | RAP60 | RAP140 | RAP220 | RAP300 | RAP380 | RAP460 | RAP540 | RAP620 | RAP700 | HU80 | HU120 | HU160 | rpd3Δ_1 | rpd3Δ_2 | rpd3Δ_3 |
|---|---|---|---|---|---|---|---|---|---|---|---|---|---|---|---|
| Cortical Patches | 0 | 0 | 0 | 0 | 0 | 0 | 0 | 0 | 0 | 0 | 0 | 0 | 0 | 0 | 0 |
| Bud | 0 | 0 | 0 | 0 | 0 | 0 | 0 | 0 | 0 | 0 | 0 | 0 | 0 | 0 | 0 |
| Bud Neck | 0 | 0 | 0 | 0 | 0 | 0 | 0 | 0 | 0 | 0 | 0 | 0 | 0 | 0 | 0 |
| Bud Site | 0 | 0 | 0 | 0 | 0 | 0 | 0 | 0 | 0 | 0 | 0 | 0 | 0 | 0 | 0 |
| Cell Periphery | 0 | 0 | 0 | 0 | 0 | 0 | 0 | 0 | 0 | 0 | 0 | 0 | 0 | 0 | 0 |
| Cytoplasm | -0.5 | -0.1 | -1.9 | -3.5 | -4.2 | -5.0 | -4.9 | -5.3 | -5.7 | 0.7 | 1.4 | 1.0 | -1.2 | -1.1 | -0.4 |
| Endoplasmic Reticulum | 0 | 0 | 0 | 0 | 0 | 0 | 0 | 0 | 0 | 0 | 0 | 0 | 0 | 0 | 0 |
| Endosome | 0 | 0 | 0 | 0 | 0 | 0 | 0 | 0 | 0 | 0 | 0 | 0 | 0 | 0 | 0 |
| Golgi | 0 | 0 | 0 | 0 | 0 | 0 | 0 | 0 | 0 | 0 | 0 | 0 | 0 | 0 | 0 |
| Mitochondria | 0.4 | 0 | 0 | 0 | 0 | 0 | 0 | 0 | 0 | 0 | 0 | 0 | 0 | 0 | 0 |
| Nucleus | 0 | 0 | 0 | 0 | 0 | 0 | 0 | 0 | 0 | 0 | 0 | 0 | 0 | 0 | 0 |
| Nuclear Periphery | 0 | 0 | 0 | 0 | 0 | 0 | 0 | 0 | 0 | 0 | 0 | 0 | 0 | 0 | 0 |
| Nucleolus | 0 | 0 | 0 | 0 | 0 | 0 | 0 | 0 | 0 | 0 | 0 | 0 | 0 | 0 | 0 |
| Peroxisomes | 0 | 0 | 0 | 0 | 0 | 0 | 0 | 0 | 0 | 0 | 0 | 0 | 0 | 0 | 0 |
| SpindlePole | 0 | 0 | 0 | 0 | 0 | 0 | 0 | 0 | 0 | 0 | 0 | 0 | 0 | 0 | 0 |
| Vacuole | 0 | 0 | 0 | 0 | 2.6 | 0 | 0 | 0 | 0 | 0 | 0 | 0 | 0 | 0 | 0 |
External localization resources
Images






























Protein Concentration and Protein Localization Data
| R1 | R2 | R3 | ||||||||||||||||
|---|---|---|---|---|---|---|---|---|---|---|---|---|---|---|---|---|---|---|
| G1 Pre-START | G1 Post-START | S/G2 | Metaphase | Anaphase | Telophase | G1 Pre-START | G1 Post-START | S/G2 | Metaphase | Anaphase | Telophase | G1 Pre-START | G1 Post-START | S/G2 | Metaphase | Anaphase | Telophase | |
| Concentration | 1.7576 | 4.6701 | 4.1253 | 3.0293 | 3.373 | 3.2545 | 1.8016 | 4.2424 | 3.6873 | 3.2008 | 3.2941 | 3.2387 | 3.7534 | 5.9889 | 5.9878 | 6.1639 | 4.8402 | 5.2726 |
| Actin | 0.0144 | 0.0002 | 0.0106 | 0.0004 | 0.0001 | 0.0029 | 0.0167 | 0.0005 | 0.0285 | 0.0048 | 0.0007 | 0.0054 | 0.0047 | 0.0005 | 0.0209 | 0.0071 | 0.0001 | 0.0125 |
| Bud | 0.0017 | 0.0002 | 0.0002 | 0.0002 | 0.0001 | 0.0001 | 0.0006 | 0.0002 | 0.0011 | 0.0011 | 0.0004 | 0.0001 | 0.0007 | 0.0005 | 0.0006 | 0.0005 | 0 | 0.0002 |
| Bud Neck | 0.0008 | 0.0003 | 0.0077 | 0.0003 | 0.0002 | 0.0021 | 0.001 | 0.0002 | 0.0025 | 0.0011 | 0.0004 | 0.0009 | 0.0009 | 0.0002 | 0.002 | 0.0009 | 0.0003 | 0.001 |
| Bud Periphery | 0.0004 | 0.0001 | 0.0002 | 0.0001 | 0 | 0 | 0.0006 | 0.0001 | 0.0013 | 0.001 | 0.0004 | 0.0001 | 0.0003 | 0.0002 | 0.0004 | 0.0005 | 0 | 0.0001 |
| Bud Site | 0.001 | 0.0013 | 0.0007 | 0.0002 | 0.0001 | 0.0001 | 0.0033 | 0.0009 | 0.0057 | 0.0059 | 0.0001 | 0.0001 | 0.0014 | 0.0034 | 0.0078 | 0.0017 | 0 | 0.0002 |
| Cell Periphery | 0.0001 | 0.0001 | 0.0001 | 0 | 0 | 0 | 0.0002 | 0.0001 | 0.0002 | 0.0001 | 0 | 0 | 0.0001 | 0.0001 | 0.0002 | 0.0002 | 0 | 0 |
| Cytoplasm | 0.8494 | 0.9461 | 0.9171 | 0.9227 | 0.915 | 0.9333 | 0.7021 | 0.9335 | 0.8697 | 0.7589 | 0.914 | 0.9416 | 0.787 | 0.9328 | 0.8764 | 0.8109 | 0.9892 | 0.8921 |
| Cytoplasmic Foci | 0.0121 | 0.0046 | 0.0032 | 0.0039 | 0.0182 | 0.0088 | 0.0365 | 0.0043 | 0.0095 | 0.0637 | 0.0033 | 0.0116 | 0.0302 | 0.0048 | 0.0109 | 0.0288 | 0.0015 | 0.0087 |
| Eisosomes | 0.0001 | 0 | 0.0001 | 0 | 0 | 0.0001 | 0.0002 | 0 | 0.0001 | 0 | 0 | 0 | 0 | 0 | 0.0001 | 0.0003 | 0 | 0.0002 |
| Endoplasmic Reticulum | 0.0069 | 0.0018 | 0.0029 | 0.0025 | 0.0049 | 0.0023 | 0.0068 | 0.0015 | 0.0036 | 0.0024 | 0.0015 | 0.0018 | 0.0033 | 0.0012 | 0.0015 | 0.0016 | 0.0004 | 0.0021 |
| Endosome | 0.0072 | 0.0025 | 0.0052 | 0.0019 | 0.0176 | 0.0034 | 0.0379 | 0.0016 | 0.0115 | 0.0491 | 0.0134 | 0.0073 | 0.0066 | 0.0007 | 0.0122 | 0.0115 | 0.0003 | 0.013 |
| Golgi | 0.0008 | 0.0001 | 0.0016 | 0.0001 | 0.0002 | 0.0003 | 0.0082 | 0.0001 | 0.0032 | 0.0118 | 0.0085 | 0.0007 | 0.0056 | 0.0002 | 0.0086 | 0.0064 | 0 | 0.0133 |
| Lipid Particles | 0.0025 | 0.0001 | 0.0018 | 0 | 0.0002 | 0.0005 | 0.0148 | 0 | 0.0019 | 0.004 | 0.0008 | 0.0001 | 0.0402 | 0 | 0.006 | 0.011 | 0 | 0.0019 |
| Mitochondria | 0.0004 | 0.0002 | 0.0009 | 0.0002 | 0.0003 | 0.0002 | 0.0098 | 0.0001 | 0.0054 | 0.0076 | 0.024 | 0.0003 | 0.002 | 0.0002 | 0.0088 | 0.0079 | 0 | 0.003 |
| None | 0.0851 | 0.0339 | 0.0278 | 0.0584 | 0.0342 | 0.0311 | 0.1197 | 0.0508 | 0.0397 | 0.0096 | 0.0158 | 0.0069 | 0.0695 | 0.0473 | 0.0167 | 0.0644 | 0.0029 | 0.0371 |
| Nuclear Periphery | 0.0028 | 0.0015 | 0.0044 | 0.0014 | 0.0014 | 0.0016 | 0.0054 | 0.0008 | 0.0022 | 0.0029 | 0.0017 | 0.0016 | 0.0015 | 0.0006 | 0.0019 | 0.0034 | 0.0004 | 0.0012 |
| Nucleolus | 0.0001 | 0.0001 | 0.0001 | 0 | 0.0001 | 0.0001 | 0.0008 | 0.0001 | 0.0002 | 0.0003 | 0 | 0 | 0.0001 | 0 | 0.0007 | 0.0014 | 0 | 0.0001 |
| Nucleus | 0.0051 | 0.0047 | 0.0122 | 0.0061 | 0.0035 | 0.0091 | 0.0068 | 0.0038 | 0.0053 | 0.0124 | 0.0104 | 0.0142 | 0.0031 | 0.0052 | 0.0112 | 0.0072 | 0.0044 | 0.0104 |
| Peroxisomes | 0.0019 | 0.0001 | 0.0005 | 0.0001 | 0.0001 | 0.0004 | 0.0147 | 0.0001 | 0.0048 | 0.0523 | 0.0001 | 0.0049 | 0.0401 | 0.0007 | 0.0075 | 0.0289 | 0 | 0.0015 |
| Punctate Nuclear | 0.005 | 0.0009 | 0.002 | 0.0006 | 0.001 | 0.0028 | 0.0068 | 0.0006 | 0.002 | 0.0055 | 0.0008 | 0.0012 | 0.0015 | 0.0006 | 0.0024 | 0.0029 | 0.0002 | 0.0009 |
| Vacuole | 0.0019 | 0.001 | 0.0007 | 0.0006 | 0.0026 | 0.0007 | 0.0058 | 0.0006 | 0.0014 | 0.0038 | 0.0017 | 0.001 | 0.0009 | 0.0005 | 0.0028 | 0.0016 | 0.0001 | 0.0005 |
| Vacuole Periphery | 0.0003 | 0.0001 | 0.0002 | 0.0001 | 0.0005 | 0.0002 | 0.0012 | 0.0001 | 0.0003 | 0.0015 | 0.0019 | 0.0002 | 0.0003 | 0.0001 | 0.0004 | 0.0008 | 0 | 0.0002 |
Sequencing Data
| R1 | R2 | |||||||||
|---|---|---|---|---|---|---|---|---|---|---|
| G1 Post-START | S/G2 | Metaphase | Anaphase | Telophase | G1 Post-START | S/G2 | Metaphase | Anaphase | Telophase | |
| Gene Expression | – | – | – | – | – | – | – | – | – | – |
| Translational Efficiency | – | – | – | – | – | – | – | – | – | – |
Hit Data
| Dataset | Hit |
|---|---|
| Protein Concentration | ✔ |
| Protein Localization | ✘ |
| Gene Expression | – |
| Translational Efficiency | – |
Endocytosis
| Temp | Actin Patch (Sac6-tdTomato) | Cortical Patch (Sla1-GFP) | Late Endosome (Snf7-GFP) | Vacuole (Vph1-GFP) |
|---|---|---|---|---|
| 37℃ | ||||
| RT |
Cell Cycle Omics
CYCLoPs (Ykl102c-GFP)
| Gene / Allele | Actin Patch (Sac6-tdTomato) | Cortical Patch (Sla1-GFP) | Late Endosome (Snf7-GFP) | Vacuole (Sac6-tdTomato) |
|---|
| Gene | Images |
|---|
| Gene | Images |
|---|
Images are not yet available
Images are not yet available